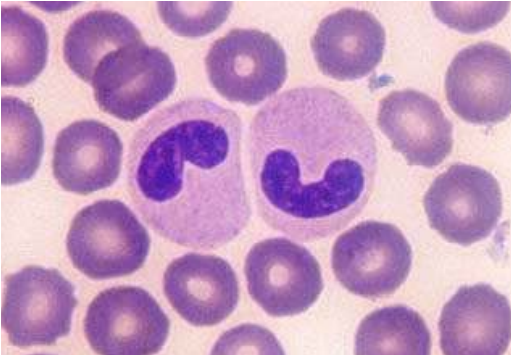
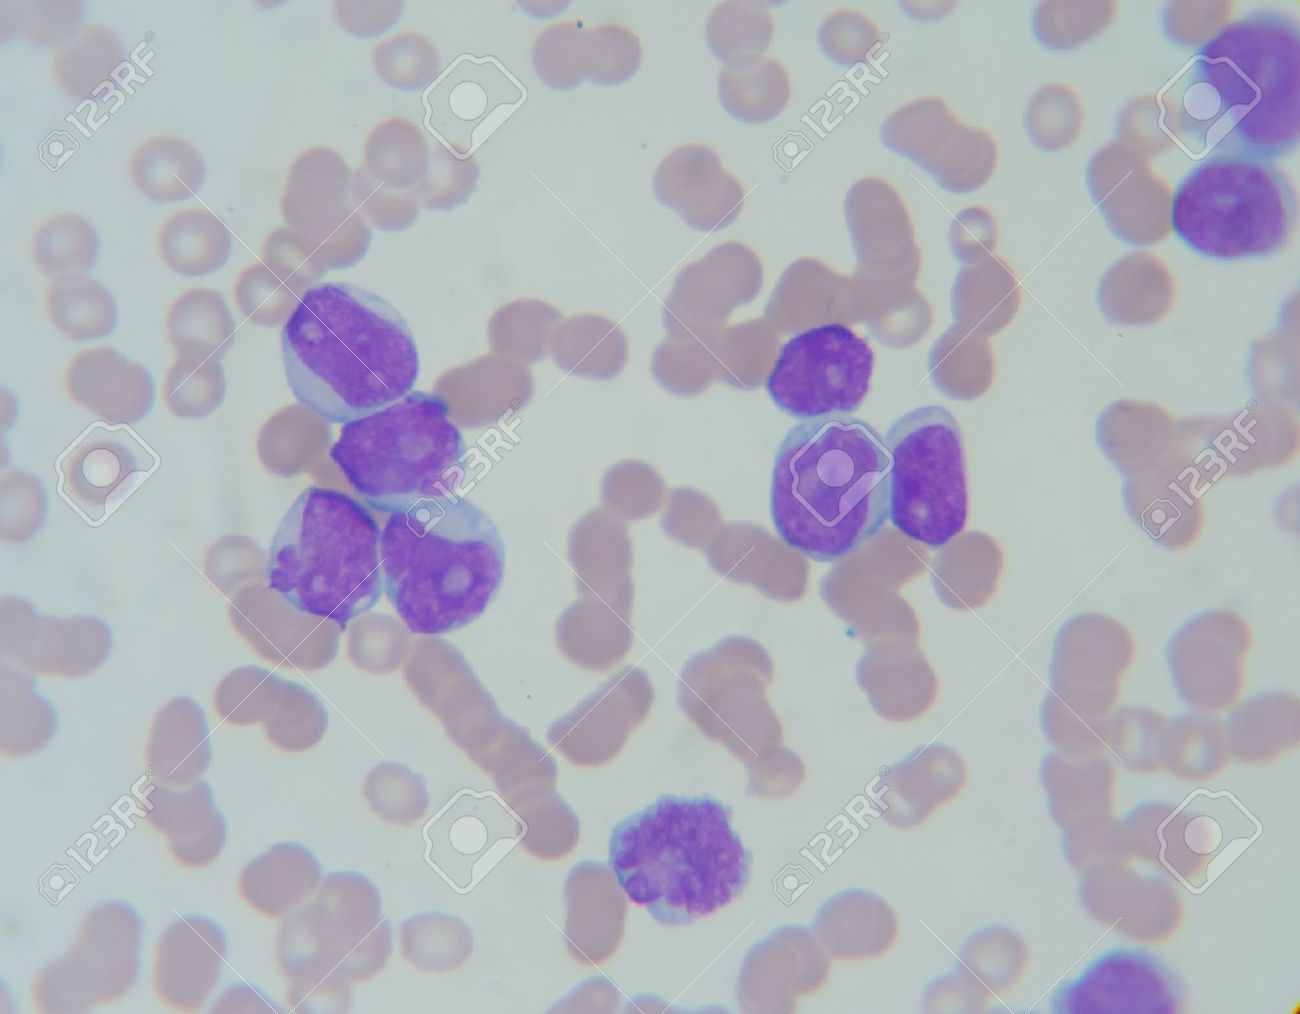
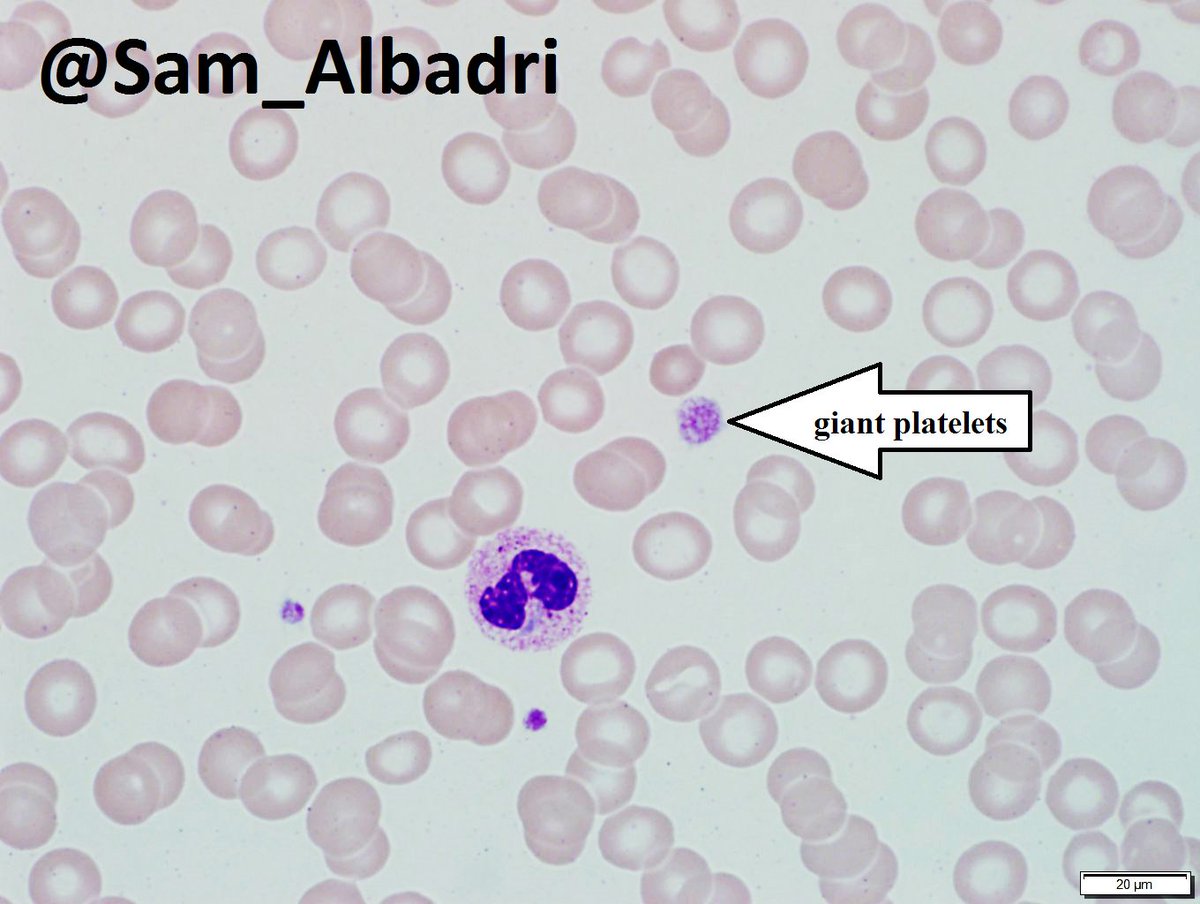

Пельгеровские нейтрофилы
Как правильно нездоров
Подать декларацию в казахстане
Ноггано кто поет
Ялта сколько гостиниц
Библиотека тукая нижнекамск
Почему у щенка той терьера
Лил трей
Бесплатные иконки в бс
Расписание электричек киевского направления от москвы селятино
Открытие вирусов функциональная грамотность ответы 9 класс
X trac
Электромагнитный клапан jcb
Натрия пикосульфат что это
Пельгеровские нейтрофилы 107 фотографий